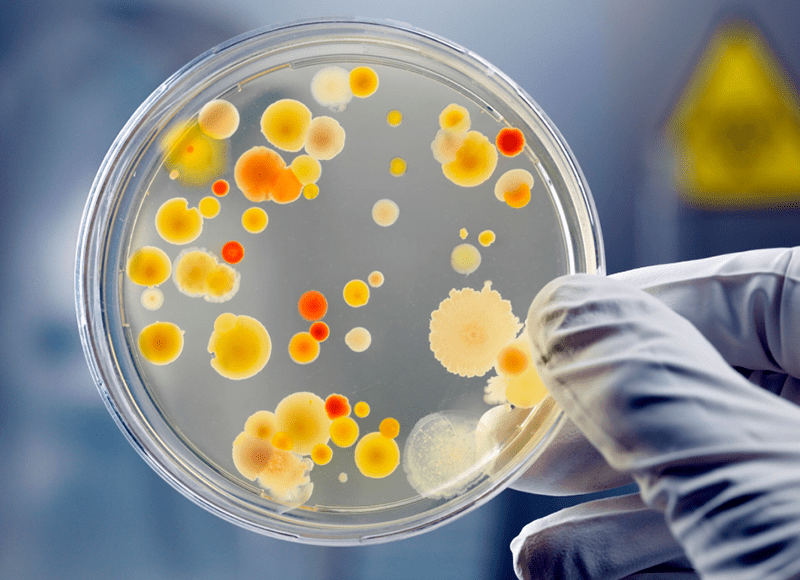

Antibakteriyel ve Antimikrobiyal Nedir, Aralarındaki Temel Farklar Nelerdir?
Antimikrobiyal ve antibakteriyel kavramları sıklıkla birbirinin yerine kullanılır, oysa gerçekte her iki terim de çok farklı anlamlar taşımaktadır. Bakteri, protozoan, küf, mantar ve virüs gibi farklı organizma türleri insanlarda ve hayvanlarda enfeksiyon ve hastalıklara neden olabilir. Mikroorganizmaların patojenitesini önlemek için kullanılan antibiyotikler, antiseptikler ve dezenfektanlar gibi maddelere antimikrobiyal madde denir. Antimikrobiyal geniş bir terimdir, antibakteriyel ise spesifik bir antimikrobiyal türüdür. Antimikrobiyal ve antibakteriyel tedaviler arasındaki temel fark, etki ettikleri mikroorganizmanın türü ve etkisinin gücüdür. Bir antibakteriyel madde çok çeşitli bakterileri öldürür, büyümelerini aktif olarak önler. Bir antimikrobiyal madde ise hepsi bir arada antibakteriyel (bakterilerin patojenik aktivitesini engeller), antibiyotik, antifungal (konakçıdaki mantar aktivitesini önler), antiparazitik (patojenik parazitlerin büyümesini önler) ve antiviral (bir virüsün patojenik etkisini durdurur) madde gibi davranarak çok daha geniş bir koruma kapsamı sunar. Antimikrobiyal maddeler yüzeylerdeki mikropların büyümesini çok uzun süre, sürekli olarak engelleyerek antibakteriyellerin sunabileceğinin ötesinde daha yüksek düzeyde ürün koruması sağlar. Evlerde, iş yerlerinde, temizliğin kritik olduğu ticari mutfaklarda, okullarda veya hastanelerde bakteriler, protozoalar, mayalar, mantarlar, virüsler, bazı algler ve hatta bazı solucanlar da dahil olmak üzere, potansiyel olarak zararlı mikroskobik organizmalara karşı antimikrobiyal ürünler bulunabilir.
Antimikrobiyal Ürünlerin Yasal Düzenlenmesi
Antimikrobiyal temizleyiciler, ABD Çevre Koruma Ajansı (EPA) tarafından pestisitler olarak, ABD Gıda ve İlaç İdaresi (FDA) tarafından ise ilaç/antiseptik olarak sınıflandırılmakta ve düzenlenmektedir. Pestisitler (böcek, haşere veya tarım ilaçları) kelimesi kulağa korkutucu gelebilir, ancak antimikrobiyaller organizmaları öldürdükleri için bu şekilde düzenlenmiştir. Yani aslında göründüğü kadar endişe verici değildir.
Pestisit olarak antimikrobiyal ürünler tezgahlar, oyuncaklar, market arabaları ve hastane ekipmanları gibi nesneler üzerinde kullanılmaktadır. Bir ürünün etiketinin herhangi bir yerinde “EPA” yazıyorsa, bunun bir pestisit olduğu ve vücutta kullanıma yönelik olmadığı anlaşılmalıdır. Bir ürün etiketi, bir zararlıyı öldürdüğünü, kontrol ettiğini, uzaklaştırdığını, hafiflettiğini veya azalttığını iddia ediyorsa bu, ABD EPA tarafından düzenlenen bir pestisittir. Üreticiler etikette bu tür bir iddiada bulunduklarında etiket, zararlıyı öldürmede veya kontrol etmede etkili olan uygulama talimatlarını ve kazara maruz kalma durumunda ilk yardım talimatlarını da içermelidir.
Antiseptikler yaralı dokulara, kesiklere ve enfekte cilt yüzeylerine uygulanır. Antiseptiklerin ağız yoluyla alınması önerilmemektedir. Antiseptik örneklerinden biri olan Dettol, kloroksilenol ve terpineolün bir karışımıdır, yaralara sürmek için kullanılır. İyot tentürü (Tentürdiyot) ve iyodoform çok iyi antiseptik özelliklere sahiptir. Borik asit, gözler için antiseptik ajan olarak kullanılır.
Halk Sağlığına Yönelik Antimikrobiyaller
ABD Çevre Koruma Ajansı (EPA), halk sağlığına yönelik antimikrobiyalleri, mikroorganizmaları yok etmede ne kadar etkili olduklarına bağlı olarak bakteriyostatlar, sanitizerler, dezenfektanlar ve sterilizatörler olarak sınıflandırır.
*Bakteriyostatlar, cansız ortamlarda bakteri üremesini engeller.
*Sanitizerler, belirli bir zaman aralığında mikroorganizmaların belirli bir yüzdesini öldüren maddelerdir. Sanitizerler en zayıf halk sağlığı antimikrobiyalleridir. Genel olarak sert yüzeylerin temizliğinde kullanılırlar. Bazı sanitizerler tezgahlar, kesme tahtaları veya çocukların mama sandalyeleri gibi gıdayla temas eden yüzeylerde, bazıları ise yalnızca klozet ve halı gibi gıdayla temas etmeyen yüzeyler veya hava için kullanılabilir. Etiket, bir sanitizerin nasıl kullanılabileceğini gösterecektir. Etki göstermeleri için gereken süre 30 saniye ila 5 dakikadır. Etkileri sınırlı mikrobisitlerdir. Spreyler, sıvılar, jeller, granüller gibi formülasyonlara sahip olabilirler.
*Dezenfektanlar, bakteri ve mantarları öldürür veya büyümesini engeller ancak sporları yok etmezler. Bazı dezenfektanlar belirli virüsleri hedef alır. Mikropları öldüren dezenfektanlara mikrobisitler denir, ancak mikrobu öldürmeden yalnızca mikrobiyal büyümeyi durdururlarsa mikrobistatlar olarak adlandırılırlar. Dezenfektanlar, tıbbi ortamlarda genel yüzeyler için tercih edilen halk sağlığı antimikrobiyalleridir. Dezenfektanlar aynı zamanda konut ortamlarında da kullanılmaktadır. Farklı ürünler yüzme havuzlarını arındırır, nevresim, tuvalet ve küvet gibi evdeki yüzeyleri dezenfekte eder. Dezenfektanların sanitizerlerden daha fazla patojeni öldürmelerinin nedeni daha yoğun olmalarıdır. Dezenfektanlar tıbbi veya konut ortamlarında ya da başka yerlerde kullanılsa da gıdayla temas eden yüzeylerde kullanılamaz. Etki göstermeleri için gereken süre genellikle 10 dakikadır. Spreyler, sıvılar, jeller, granüller gibi formülasyonlara sahip olabilirler.
*Sterilizatörler, en güçlü halk sağlığı antimikrobiyal ürünleridir. Bakteriler, algler ve mantarların yanı sıra öldürülmesi zor sporları da kontrol ederler. Mikrobisit olarak etki gösterirler. Sterilizatörlerin çoğu sınırlı kullanımlı pestisitlerdir. Bunlar uygulayıcı eğitim ve sertifikasyon gerektirir. Sterilizatörler, mikropların varlığının mümkün olduğu kadar önlenmesi gereken tıbbi ve araştırma ortamlarında, tıbbi aletler ve araştırma malzemeleri için kullanılır. Malzemelerin sterilizasyonunda kimyasal sterilizatörlerin yanı sıra yüksek basınçlı buhar ve fırınlar da kullanılmaktadır. Etki göstermeleri için gereken süre değişkendir. Sıvı ve gaz gibi formülasyonlara sahip olabilirler.
Antimikrobiyal Teknolojiler
Antimikrobiyal bir ürün, kullanılacağı ortama ve ihtiyaca göre antibakteriyel, antifungal veya her ikisini birden bulunacak şekilde üretilebilir. Çeşitli sektörlerdeki ürünlerin daha temiz, daha taze ve daha uzun süre dayanıklı kalmasına yardımcı olmak için yerleşik antimikrobiyal teknolojiler kullanılır. Antimikrobiyal teknolojiler tekstil, yapı (inşaat) malzemeleri, sağlık bakım ürünleri, ticari yüzeyler, yiyecek ve içecek servis ürünleri, tüketici ürünleri, nakliye malzemeleri, eğitim ortamları gibi çok çeşitli sektörlerdeki ürünlere yerleştirilebilirler. Antimikrobiyal ürünler kullanılırken her zaman etiket talimatları izlenmelidir. Kullanım talimatları spesifiktir ve bunlara uyulmazsa ürün işe yaramayabilir. Farklı antimikrobiyal ürünler asla karıştırılmamalıdır. Çoğu antimikrobiyal ürünün etki göstermesi zaman alır. Ürünün sanitize edilmesi, dezenfekte edilmesi veya sterilize edilmesi için yüzeyle ne kadar süre temas halinde kalması gerektiğini öğrenmek için etiket okunmalıdır. Kir, yiyecek, çamur ve diğer parçacıklar antimikrobiyal ürünlerin etkinliğini azaltabilir. Antimikrobiyal pestisitlere maruz kalma oranını azaltmak için gerekli adımlar atılmalıdır. Bazı ürünler dokunulduğunda veya solunduğunda zararlı olabilir.
Antimikrobiyallerin Ekolojik Etkileri
İster doğal ister insan yapımı olsun antimikrobiyaller, farklı ekosistemler üzerinde güçlü bir etkiye sahip olan mikro kirleticilerdir. Her yıl birkaç bin ton antimikrobiyal madde ve bunların yan ürünleri çevreye, özellikle de su ortamına salınmaktadır. Ek olarak, bazı antimikrobiyaller çevrede özellikle kalıcıdır ve bu da onların farklı kısımlarda yayılmasını ve birikmesini kolaylaştırır. Bu tür ksenobiyotiklerin (organizmalar için yabancı, gereksiz kimyasal bileşikler) doğal ortamda ekolojik sonuçları olduğu gibi aynı zamanda atık su arıtma tesisleri ve metan fermantasyon kanalizasyon çamuru arıtma tesisleri gibi teknolojik ortamlarda da sonuçları vardır. Mikrobiyal toplulukların yalnızca yüksek konsantrasyonlara değil aynı zamanda alt inhibitör konsantrasyonlara da sürekli maruz kalması, su ortamlarında ve toprakta antibiyotik direncinin gelişmesinde anahtar bir unsurdur. Ekolojik etkilerini anlamak ve nasıl kontrol edileceğini öğrenmek için çalışmalara ihtiyaç vardır. Antimikrobiyallerin geleceği biyolojik kaynaklı veya biyo-ilhamlı (biyolojiden esinlenen) moleküllerin geliştirilmesinde yatmaktadır. Canlı organizmalar arasındaki etkileşimlerin gözlemlenmesi ve deşifre edilmesi bu gelişimin anahtarıdır.